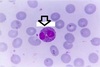
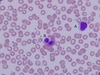

Histology Identification Flashcards
(41 cards)

skeletal muscle, neuromuscular junction
Identify tissue and structures

A: Intercalated Disc, B: L line, cardiac muscle

A Intercalated disc, B: Nucleus
Identify tissue and structures

Smooth muscle; A smooth muscle, B: Nucleus, CNucleus, D smooth muscle
Identify tissue type.

cardiac muscle

a) skeletal muscle fiber, b) motor end plate

A) I band B) Mitochondria ;Skeletal muscle EM

skeletal muscle; a) mitochondria b) nucleus c) A band d) I band

a) M line, b) I band c) H band d) z disc; skeletal muscle

skeletal muscle EM; a) I band b) z disc, c) A band

smooth muscle

A) oseton B) Haversian Canal C) Concentric Lammela D) Volkmans Canal

A) Volkmans Canal B Intermediate Lamella

A)Chondrocyte B) Chondroblast C) Perichondrium

A) resting zone B) hypertrophy of chondrocytes C) Proliferation zone D) Calcification

A) Isogenic group B) Perichondrium C) Fibers

A) Isogenic Group B) Territorial matrix C) Interterritorial matrix

Elastic Fibers, Elastic Cartilage

A)Chondrocytes B)Perichondrium C) Elastic Fibers

A) Chondroblast B) Chondrocyte c) Elastic fibers

A) fibrocartilage b) proliferation zone c) hypertrophic chondrocytes d) Bone Marrow e) New bone

Fibrocartilage a) collagen b) chondrocytes

Fibrocartilage

a) Chondrocytes in Row b) chondrocytes alone c) Lacuna